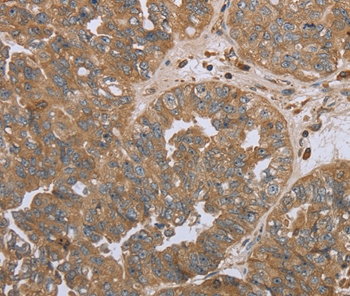
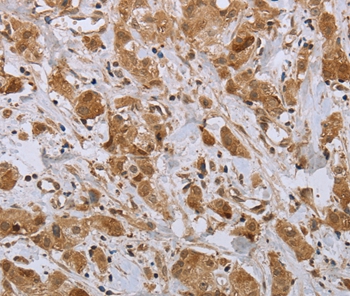
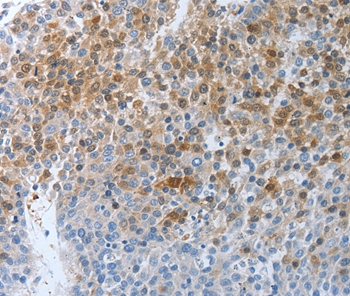
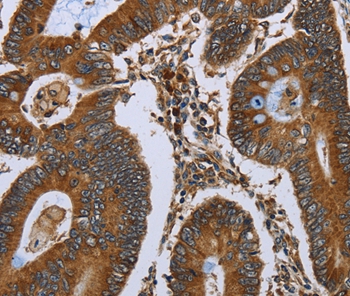

-
分类: 科研抗体货号: P42945别名: FDP; MIAL1应用: IHC反应种属: Human
-
分类: 科研抗体货号: P42927别名: GB1; GPRC3A; GABABR1; GABBR1-3; dJ271M21.1.1; dJ271M21.1.2应用: IHC反应种属: Human,Mouse,Rat
-
分类: 科研抗体货号: P42905别名: TIG1应用: WB,IHC反应种属: Human
-
分类: 科研抗体货号: P42944别名: MOX1; NOH1; NOH-1; GP91-2应用: IHC反应种属: Human
-
分类: 科研抗体货号: P42926别名: FGF-20应用: IHC反应种属: Human,Mouse,Rat
-
分类: 科研抗体货号: P42903别名: SSeCKS; AKAP250应用: WB,IHC反应种属: Human
-
分类: 科研抗体货号: P42943别名: AMDM; ANPb; NPRB; ANPRB; GUC2B; NPRBi; GUCY2B应用: IHC反应种属: Human,Mouse
-
分类: 科研抗体货号: P42925别名: FGF-22应用: IHC反应种属: Human,Mouse
-
分类: 科研抗体货号: P42902别名: DEP1; SCC1; CD148; HPTPeta; R-PTP-ETA应用: IHC反应种属: Human
-
分类: 科研抗体货号: P42942别名: NEFA; HEL-S-109应用: WB,IHC反应种属: Human

鄂公网安备42018502007531号
鄂公网安备42018502007531号

